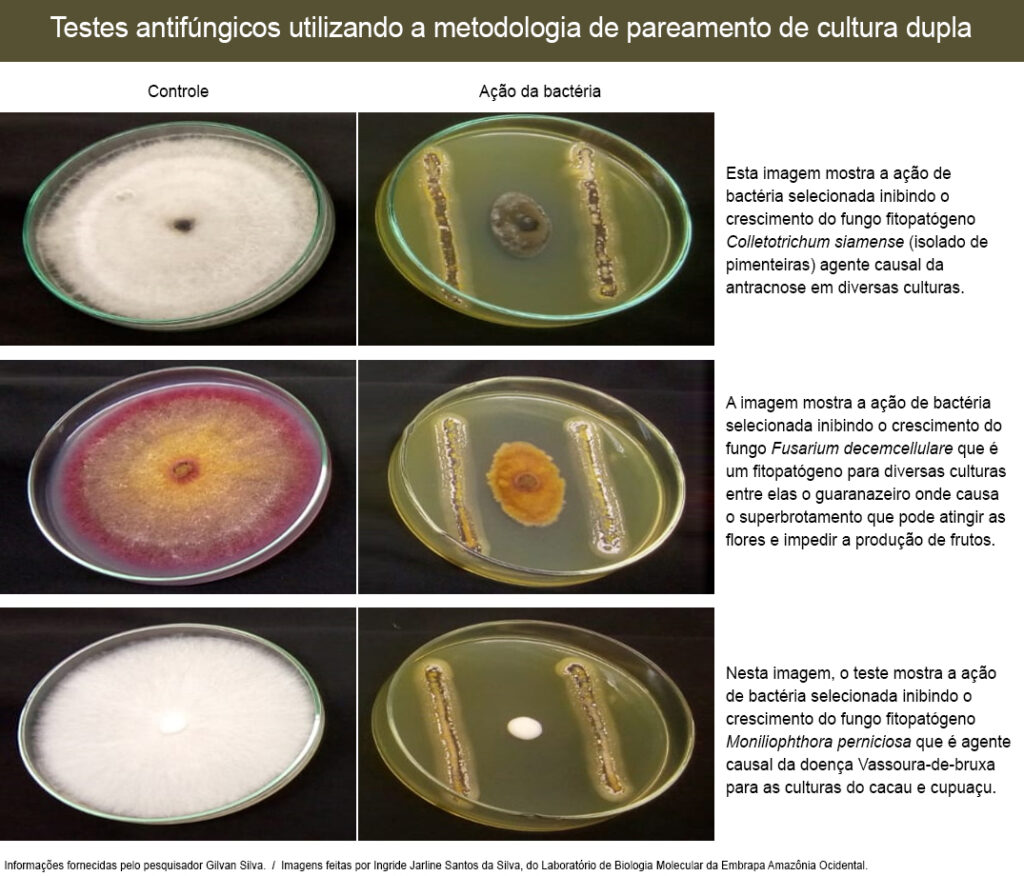

Inovação
Embrapa descobre tesouro biotecnológico para o agro na Amazônia
Primeiro estudo em larga escala nos rios amazônicos confirmou microrganismos com potencial para uso agrícola
Cientistas da Embrapa, em Manaus (AM), estão realizando pesquisas com microrganismos coletados de sedimentos de rios amazônicos e identificaram bactérias e fungos com potencial biotecnológico.
Esses pequenos seres podem gerar valiosas moléculas para uso médico e agrícola ou para aplicação em processos industriais, segundo explica o pesquisador da Embrapa Amazônia Ocidental Gilvan Ferreira da Silva, que coordena o trabalho.
Ele destaca que esse é o primeiro estudo em larga escala utilizando microrganismos cultiváveis e não cultiváveis presentes nos sedimentos da Bacia Amazônica. Eles percorreram quase 7 mil km de rios para fazer o levantamento.
Segundo o cientista, o trabalho combina diferentes ferramentas em uma pesquisa multidisciplinar integrando microbiologia, química e genômica (sequenciamento de genomas completos, edição gênica e metagenômica).
Segundo o cientista, o trabalho combina diferentes ferramentas em uma pesquisa multidisciplinar integrando microbiologia, química e genômica (sequenciamento de genomas completos, edição gênica e metagenômica).
“O interesse não está apenas na identificação de microrganismos com potencial biotecnológico. O importante é identificar a química das moléculas com bioatividade, os genes e vias de biossíntese desses compostos”, disse.
Com isso, será possível maximizar a produção dos compostos de interesse por meio da edição gênica.
Após a coleta, a equipe do Laboratório de Biologia Molecular da Embrapa Amazônia Ocidental realizou a análise de mais de mil microrganismos obtidos dos sedimentos dos rios.
No Laboratório de Biologia Molecular da Embrapa Amazônia Ocidental (AM) está sendo realizado o isolamento dos microrganismos cultiváveis e as extrações de DNA para estudos de metataxonomia e metagenômica funcional.
Estima-se que apenas 5% dos microrganismos são cultiváveis. Para eles, a meta para este ano é obter o genoma completo de mais de 60 bactérias já selecionadas. Entre elas, fungos e bactérias de interesse agrícola capazes de combater fitopatógenos e disponibilizar nutrientes para as plantas.
Silva informa que no caso dos microrganismos não cultiváveis (aqueles incapazes de crescer em meio de cultura) e que são a maioria da microbiota, o projeto pretende extrair o DNA dos sedimentos e, por meio de diferentes plataformas de sequenciamento, obter os genomas ambientais e por eles identificar genes e vias metabólicas.
O grupo vem ganhando expertise na análise de genomas voltados para produção de metabólitos secundários.
À procura de moléculas com ação antiparasitária e anticâncer
No ano passado, foi realizado o sequenciamento de nove genomas completos de fungos isolados da Amazônia com potencial biotecnológico, dos quais cinco são novas espécies.
Esses genomas estão em análise para identificação das vias metabólicas relacionadas à produção de moléculas de interesse, principalmente de ação antimicrobiana, antiparasitária e anticâncer.
Além de contribuir para o estudo da biodiversidade amazônica e identificação de novas espécies de microrganismos, a pesquisa está permitindo a capacitação e maior domínio no uso de tecnologias de ponta na biologia molecular e também o avanço para resultados com aplicação prática para diversos segmentos industriais.
Silva informa que os microrganismos foram selecionados de acordo com a atividade que apresentam. “Os mais promissores estão sendo identificados por meio da morfologia e da filogenia molecular”, acrescenta ele.
Aplicação agrícola
Alguns têm atividade antimicrobiana contra fitopatógenos de interesse agrícola. Como exemplo, foram selecionados produtores de moléculas antimicrobianas com potencial de aplicação em diversas cadeias produtivas da agricultura, como no controle de fitopatógenos para as culturas do guaranazeiro, fruteiras amazônicas (cupuaçu, cacau) e hortaliças.
O controle de doenças em culturas agrícolas, por exemplo, é capaz de melhorar a produção e renda de pequenos e grandes agricultores e também reduzir o uso de defensivos químicos com consequentes impactos positivos ao meio ambiente e à saúde humana.
Foram selecionados microrganismos que agem na produção de enzimas, como protease, amilase, lipase e celulase, que por sua vez têm aplicação em diversas indústrias. As celulases são usadas para amaciamento de fibras de jeans e para a indústria de celulose e também para uso no bioetanol.
Já a lipase, além de aplicação no setor têxtil, também é usada na produção de detergentes, indústria do couro e flavorizantes para alimentos. A amilase é utilizada na indústria alimentícia e a protease tem várias aplicações, como na produção de detergentes e biodiesel.
Também foram selecionados microrganismos que agem na produção de sideróforo (moléculas quelantes de íons férricos que permitem assimilação de ferro do solo). Essas moléculas de sideróforo formam ligações estáveis com o ferro, permitindo torná-lo solúvel e transportá-lo para locais de interesse.
Foram encontrados ainda microrganismos que agem na solubilização de fosfatos, ou seja, permitem a disponibilização do fósforo, que se encontra normalmente em sua forma insolúvel nos solos. Essas atividades são importantes para disponibilizar nutrientes para as plantas.
Silva destaca que nesses estudos está sendo adotada a integração de técnicas de ponta, como sequenciamento em larga escala para a obtenção de genomas completos e a edição gênica via CRISPR-CAS9, combinada à identificação química das moléculas produzidas pela microbiota amazônica.
“Essa integração permite avançar na análise funcional das rotas bioquímicas relacionadas às moléculas de interesse e na obtenção de linhagens de microrganismos superprodutores de moléculas de alto valor, assim como em estudos de ponta integrando genômica e química”, explica.
A futura aplicação desses resultados servirá ao desenvolvimento de bioprodutos com base na microbiota amazônica. Além disso, o trabalho tem importância científica, permitindo avanços nas áreas de biologia molecular, química e genômica aplicadas à microbiologia. (fonte: Embrapa)
Nesta notícia, falamos sobre a importância do biodigital para o Brasil.
Assine nossa Newsletter
Cadastra-se no Ag Evolution e conheças as principais empresas de tecnologia do mundo Agro



